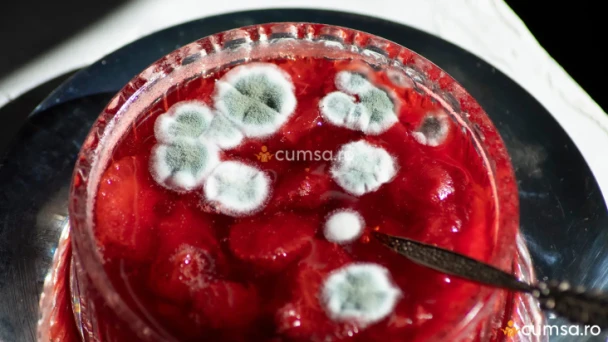

TEXT HEADER
Dulceata de rubarba. Cum sa pregatesti reteta clasica

Dulceata de rubarba. Afla cum sa pregatesti reteta clasica si de ce ingrediente ai nevoie. Care sunt pasii pe care sa ii urmezi pentru a obtine o dulceata absolut delicioasa.
- Reteta dulceata de rubarba. Cum sa o faci la tine acasa
- Ce este rubarba si cum arata
- 1kg rubarba
- 1kg zahar
- esenta de vanilie sau miezul de la o pastaie de vanilie
- 1 lamaie
Reteta dulceata de rubarba. Cum sa o faci la tine acasa
Reteta dulceata de rubarbaPrimul lucru pe care trebuie sa il faci atunci cand prepari dulceata de rubarba este sa cureti tijele sau petiolurile, iar apoi sa le tai in bucatele de maximum 2 cm.
Urmatorul pas va fi sa le oui intr-o oala, dupa aceea sa pui zahar peste acestea, zeama de la o lamaie, iar apoi sa adaugi si pastaia de vanilie sau o lingurita cu esenta de vanilie.
Scutura un pic oala pentru ca zaharul sa patrunda si in partea de jos, iar apoi lasa totul asa timp de 1-2 ore pana ce se va strnge siropul.
Pune oala la foc mediu si las-o sa fiarba. Atunci cand da in clocot, ar trebui sa se formeze o spuma deasupra. Ei bine, folosind o spumiera indeparteaza-o si amesteca foarte bine pana ce nu se mai formeaza.
Dulceata de rubarba ar trebui sa mai fiarba timp de 15 minute dupa ce da in clocot, asa ca da focil mic si las-o pe aragaz.
Poti testa o lingurita cu dulceata folosind un pahar de apa rece, iar daca aceasta este suficient de legata inseamna ca este gata.
Dulceata se va pune fierbinte in borcane sterilizate, iar apoi acestea se inchid cu capce. Lasa-le sa se raceasca pana a doua zi, iar apoi le poti depozita in camara sau intr-un loc racoros.
Ce este rubarba si cum arata
RubarbaIn cazul in care nu stiai, rubarba (Rheum) este o planta perena care poate atinge inaltimi de pana la 2 metri. Cu toate ca vorbim despre o planta cu frunze toxice din cauza continutului bogat de acid oxalic. Rubarba mai este cunoscuta si sub numele de revent, rabarbar sau rabarbara.
Totusi, in bucatarie se folosesc petiolurile, adica partea frunzei care este responsabila cu sustinerea limbului si care se prinde de tulpina. Acestea sunt folosite doar primavara! De cele mai multe ori, planta este folosita pentru a face dulceata de rubarba.
Citeste si: Cultivare rubarba. Cum sa cresti aceasta planta
Petiolurile de rubarba au o culoare rozalie si cu cat acestea sunt mai inchise, cu atat planta este mai acrisoara. Si daca tot am adus vorba de acrisor, ar trebui sa stii ca rubarba este bogata in vitamina C, potasiu, magneziu, fier, zinc sau fosfor.
Pe langa dulceturi, rubarba mai este folosita pentru prepararea siropurilor, dar si pentru acrirea ciorbelor. Perioada de recoltare este mai-iunie, iar dupa luna iulie aceasta va deveni amara si nu o sa o mai poti folosi.

TEXT FOOTER:









